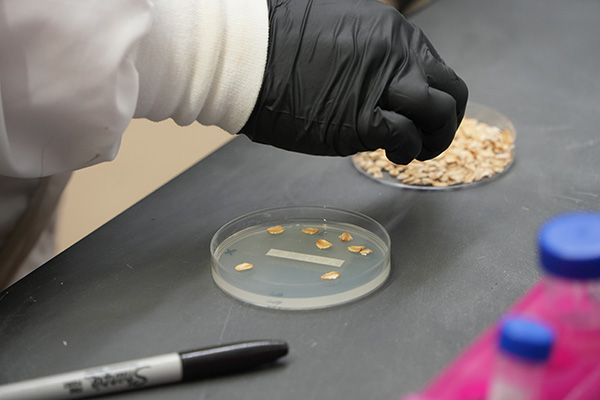
Joeanna Moore is dressed in a white lab coat and black gloves focuses on placing oat flakes into petri dishes during a lab experiment.
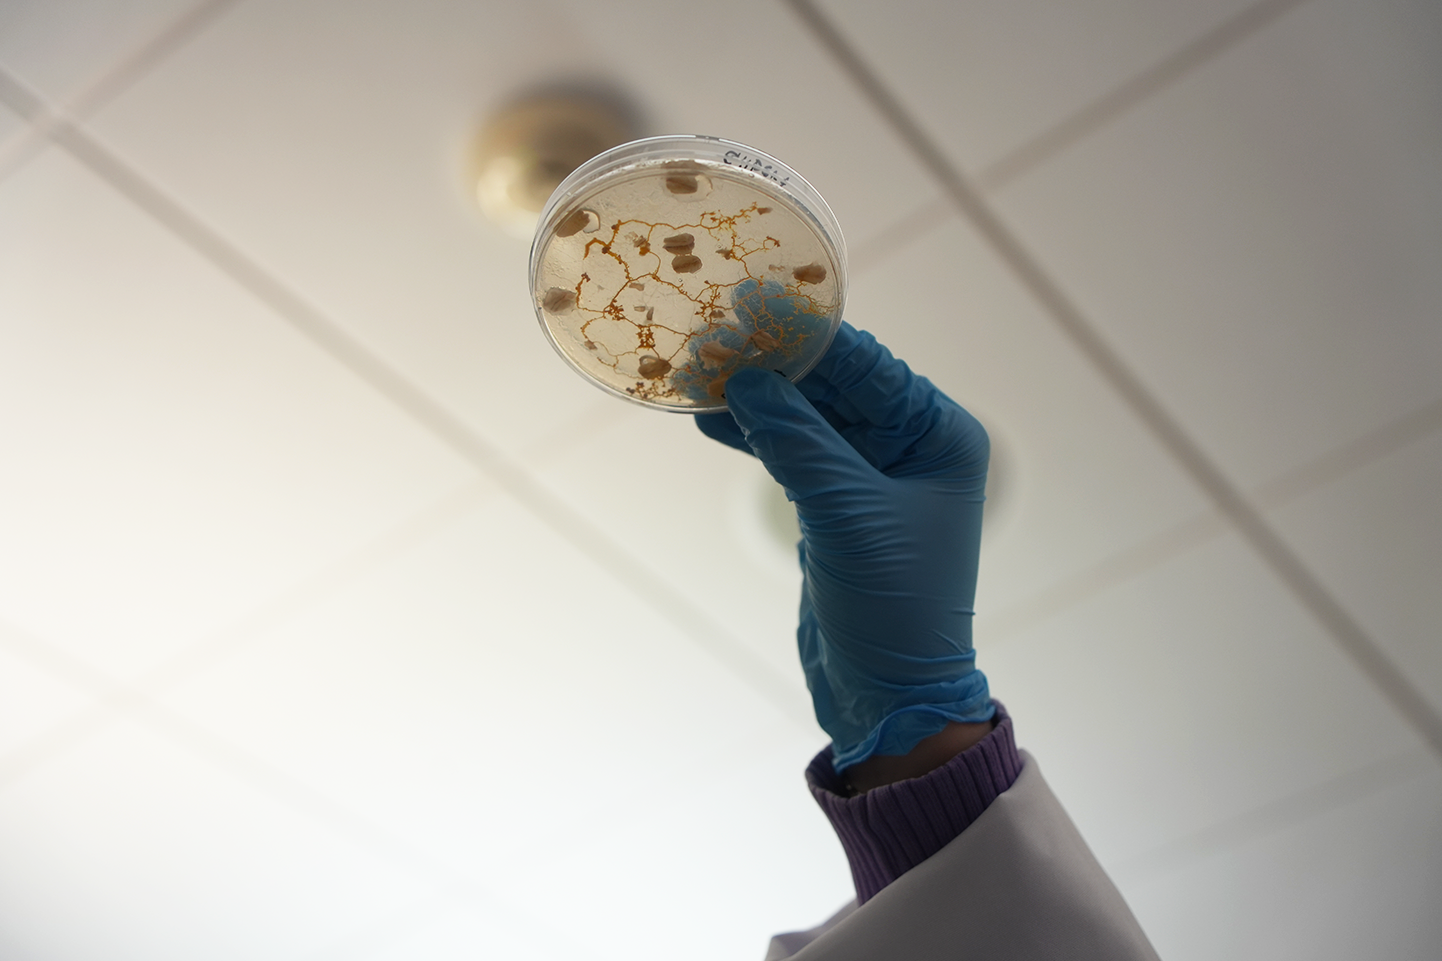
A gloved hand holds a petri dish up toward the ceiling light to inspect the sample inside, capturing a moment of scientific observation.

Joeanna Moore remembers the moment she realized something had to change. She was 28, staring at a job rejection email. It was for an entry-level office administration role, filing paperwork. She didn’t get it. Not because she lacked experience, but because she didn’t have a college degree.
“That was the moment when I was like, okay, I have to get an associate's degree,” she said. “I want something that makes me feel fulfilled. Something I actually care about.”
It had been more than a decade since high school. But that rejection pushed her forward. In fall 2023, she enrolled as a Psychology Transfer Major at Scott Community College (SCC).
Finding Solid Ground
Reentering school in her 30s wasn’t easy. Moore expected to feel out of place among younger classmates, but found the opposite.
“I ended up finding more people who thought like me than I expected,” she said. “And people who needed me to think the way I did.”
School quickly became something else: not a hurdle, but a proving ground.
 "It was a rewarding experience to come back and be who I always felt like I was, and
not have it feel overwhelming or out of place," she said. "Not having ever found my
true ground in any of the things that I had ever done before—it felt exciting to go
into something with absolutely no real expectation of how it would turn out and land
flat on my feet."
"It was a rewarding experience to come back and be who I always felt like I was, and
not have it feel overwhelming or out of place," she said. "Not having ever found my
true ground in any of the things that I had ever done before—it felt exciting to go
into something with absolutely no real expectation of how it would turn out and land
flat on my feet."
She credits her success to Eastern Iowa Community Colleges' (EICC) supportive community.
“Success doesn’t always look like what you think it will. A lot of it had to come internally from me, and that’s okay,” she said. “But the support I had at EICC? That made all the difference.”
Moore didn’t just get through school. She immersed herself in it. She worked as a student employee in the Health Sciences department, tutored peers in the SCC Tutoring Center, and joined the Phi Theta Kappa (PTK) National Honor Society. Through PTK, she helped establish Smart Recovery, a student support group for those navigating addiction or recovery.
But one of her most unexpected turning points came in the form of a bright yellow blob.
Lab Coats, Collective Behavior, and Slime Mold
 Physarum polycephalum, also known as slime mold, became the unlikely centerpiece of a cross-disciplinary
study spearheaded by Gary Buckley, SCC Psychology Instructor, and Eric Carr, SCC Political
Science Instructor.
Physarum polycephalum, also known as slime mold, became the unlikely centerpiece of a cross-disciplinary
study spearheaded by Gary Buckley, SCC Psychology Instructor, and Eric Carr, SCC Political
Science Instructor.
“You can’t take one of Gary Buckley’s classes without hearing about slime mold,” Moore said with a chuckle.
What began as casual hallway conversations turned into a formal study within weeks. The research explored how a brainless organism could model memory, adaptation, and decision-making. Moore helped lead the project, capturing lab notes, images, and time-lapse videos of the organism’s behavior.
“Based on what we see the slime mold do, given the variables that we add—things it likes or dislikes—we start thinking about theories we've all studied,” she said. “Game theory. Self-interest. Adaptation. It became this unexpected but fascinating way to explore human behavior.”
The project quickly gained momentum. Students across disciplines got involved. Additive manufacturing students 3D-printed mazes. The business department developed a nonprofit model. Ethics classes examined the responsible use of living organisms in research.
“What amazed me most was how excited everyone else got,” Moore said. “That kind of spirit was contagious. Without that energy, I don’t think it would’ve become what it did.”
A Cup of Coffee, With a Side of Columbia
Moore’s curiosity for how people think, sparked by science and sharpened through research, led her to aim higher.
Encouraged by her mentors, she applied to several schools, including Columbia University.
“I wasn’t even going to entertain applying to other schools,” she said. “I was going to keep going the way I was going. But they said, 'Just shoot your shot—what’s the worst that could happen?' I thought—they're right.”
Then came the email. Moore was accepted into Columbia.
“I was standing in a coffee line. I had already placed my order, and the barista came back with my coffee, and I was in tears,” she said. “I had already made peace with it not happening, but then it did. It was like total whiplash.”
Accepting the offer wasn’t about the Ivy League prestige. It was about the future.
“It puts me in a better position to help people,” she said. “And it puts me around people with the means to help others, too.”
The Commencement Stage
Before that Columbia acceptance email ever hit her inbox, Moore had already raised her hand to speak at SCC's Commencement Ceremony. She didn’t do it to talk about her accomplishments. She did it to reflect on the power of community, and what it means to move forward when you’re unsure where the path leads.
“I didn’t want it to be about me,” she said. “I was more concerned with what truth I could give to someone else that would make them feel less alone in their experience.”
As a psychology student, Moore understood the power of connection. She wanted her speech to be something others could see themselves in. Something that offered comfort, encouragement, and honesty about the challenges of moving forward.
"I hope they feel like if they're not in a place where they want to be, that they'll find it someday," she said. "There are going to be lonely chapters. You're going to want to give up. But if you have perspective and support, those things start to work themselves out."
Her biggest emphasis? Community. "That's kind of my big thing—bringing people back into communicating with each other in a way that's actually functional and not combative."
What Comes Next
At Columbia, Moore plans to study psychology and cognitive neuroscience. Two fields she believes are key to understanding behavior and influencing systemic change.
"I've always been fascinated by just being able to ask questions and hopefully answer them," she said. "Research just felt right to me."
When asked about her research interests, she ticked off a list. How unmet basic needs shape behavioral patterns. How food additives impact mental health. How technology and isolation affect our ability to connect.
“With research, it's all about data. Put it on paper. Give people numbers,” she said. “That kind of research can help shape policies that actually serve people.”
She doesn’t yet know where this path will lead. Maybe policy work. Maybe political office. But she knows she wants to be where change happens.
“I want to be in the rooms where decisions are made,” she said.
As she packs for New York, Moore carries with her not just notebooks and textbooks, but the confidence she gained at SCC.
“To my younger self? I’d say, don't worry about not getting that entry-level job. What you’re doing isn’t too much. Who you are isn’t too much.”
She knows what it’s like to start over. She also knows what it means to rise above.
“SCC let me be an outlier” she said. “And that made all the difference.”